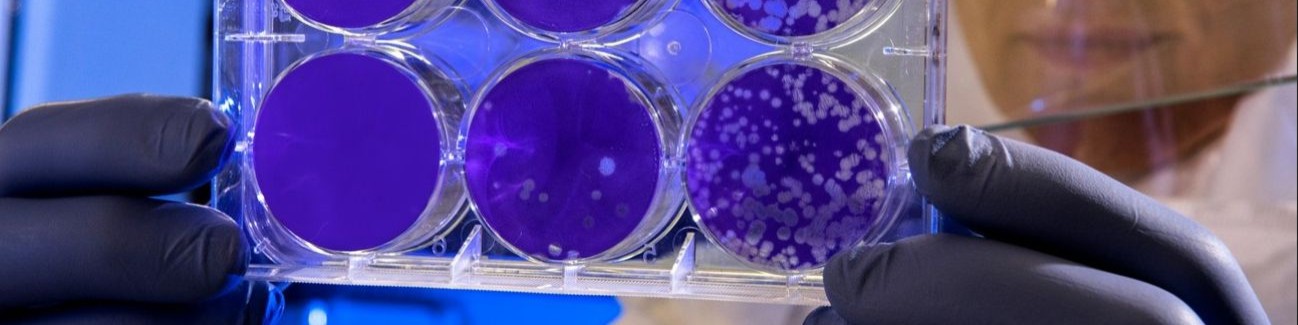

New challenges: spread of zoonoses and phage technologies in the One Health context
Seminar fee
Participation in the seminars is free of charge for scientists, university staff, and students throughout Germany. Please register using your university email address.
The project is funded by the GO-Bio initial program of the BMFTR.
Please note that your registration is binding. You can cancel your registration up to one week before the course begins without giving a reason.
Target audience
This project is suitable for master's students, doctoral candidates, postdoctoral researchers, and all academic staff in the life and natural sciences, medicine, and related fields who want to further develop their applicable ideas or inventions, ideally to the point of commercialization.
Program
The program and invitation to the seminar can be found here as a PDF file.
Speakers
Dr Kittler research is focused on the targeted use of bacteriophages to develop pioneering antimicrobial solutions against zoonoses and foodborne diseases. She was awarded the Academy for Animal Health's sponsorship award for her commitment to ensuring food quality and preserving animal and human health in line with the One Health approach.
Location
The seminar will take place online via the BigBlueButton (BBB) web conferencing system. You can open BBB via a link in your web browser. All you need to do is click on the link to join the seminar. We will send you the link by email in good time. Access will be open from 12:50 p.m.
Event Information
| Event Date | 22.04.2026 | 13:00 Uhr | ||||||||||
| Event End Date | 22.04.2026 | 14:50 Uhr | ||||||||||
| Cut Off Date | 21.04.2026 | ||||||||||
| Individual Price | Free of charge | ||||||||||
| Programm |
(Programmänderungen / Ergänzungen vorbehalten) Das Programm und der Flyer für diese Veranstaltung sind hier als PDF-Datei zu finden. |
||||||||||
| Organizer |
TransMIT Gesellschaft für Technologietransfer mbH Ihre Ansprechpartnerin: |
||||||||||
| Location | Online |

